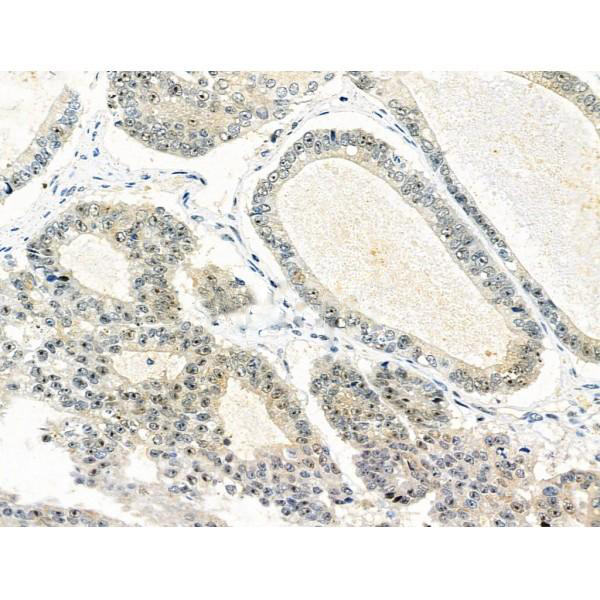

Multifunctional protein that plays a central role in the cellular response to oxidative stress. The two major activities of APEX1 are DNA repair and redox regulation of transcriptional factors. Functions as a apurinic/apyrimidinic (AP) endodeoxyribonuclease in the DNA base excision repair (BER) pathway of DNA lesions induced by oxidative and alkylating agents. Initiates repair of AP sites in DNA by catalyzing hydrolytic incision of the phosphodiester backbone immediately adjacent to the damage, generating a single-strand break with 5'-deoxyribose phosphate and 3'-hydroxyl ends. Does also incise at AP sites in the DNA strand of DNA/RNA hybrids, single-stranded DNA regions of R-loop structures, and single-stranded RNA molecules. Has a 3'-5' exoribonuclease activity on mismatched deoxyribonucleotides at the 3' termini of nicked or gapped DNA molecules during short-patch BER. Possesses a DNA 3' phosphodiesterase activity capable of removing lesions (such as phosphoglycolate) blocking the 3' side of DNA strand breaks. May also play a role in the epigenetic regulation of gene expression by participating in DNA demethylation. Acts as a loading factor for POLB onto non-incised AP sites in DNA and stimulates the 5'-terminal deoxyribose 5'-phosphate (dRp) excision activity of POLB. Plays a role in the protection from granzymes-mediated cellular repair leading to cell death. Also involved in the DNA cleavage step of class switch recombination (CSR). On the other hand, APEX1 also exerts reversible nuclear redox activity to regulate DNA binding affinity and transcriptional activity of transcriptional factors by controlling the redox status of their DNA-binding domain, such as the FOS/JUN AP-1 complex after exposure to IR. Involved in calcium-dependent down-regulation of parathyroid hormone (PTH) expression by binding to negative calcium response elements (nCaREs). Together with HNRNPL or the dimer XRCC5/XRCC6, associates with nCaRE, acting as an activator of transcriptional repression. Stimulates the YBX1-mediated MDR1 promoter activity, when acetylated at Lys-6 and Lys-7, leading to drug resistance. Acts also as an endoribonuclease involved in the control of single-stranded RNA metabolism. Plays a role in regulating MYC mRNA turnover by preferentially cleaving in between UA and CA dinucleotides of the MYC coding region determinant (CRD). In association with NMD1, plays a role in the rRNA quality control process during cell cycle progression. Associates, together with YBX1, on the MDR1 promoter. Together with NPM1, associates with rRNA. Binds DNA and RNA.
Description
Rabbit polyclonal antibody to APEX1
Applications
WB, IF, ICC, IHC.
Immunogen
APEX1 Antibody detects endogenous levels of total APEX1.
Reactivity
Human, Mouse, Rat.
可预测:Pig(91%), Bovine(%), Horse(%), Sheep(%), Rabbit(%), Dog(%)
Molecular weight
36kDa; 36kD(Calculated).
Host species
Rabbit
Ig class
Immunogen-specific rabbit IgG
Purification
Antigen affinity purification
Full name
APEX1
Synonyms
AP endonuclease 1; AP endonuclease class I; AP lyase; APE 1; APE; APE-1; APEN; APEX 1; APEX; APEX nuclease (multifunctional DNA repair enzyme) 1; Apex nuclease 1; APEX nuclease; APEX1; APEX1_HUMAN; Apurinic endonuclease; Apurinic-apyrimidinic endonuclease 1; Apurinic/apyrimidinic (abasic) endonuclease; Apurinic/apyrimidinic endonuclease 1; Apurinic/apyrimidinic exonuclease; APX; BAP1; Deoxyribonuclease (apurinic or apyrimidinic); DNA (apurinic or apyrimidinic site) lyase; DNA-(apurinic or apyrimidinic site) lyase, mitochondrial; EC 4.2.99.18; HAP 1; HAP1; Human Apurinic endonuclease 1; MGC139790; Multifunctional DNA repair enzyme; Redox factor 1; Redox factor-1; REF 1; REF 1 protein; REF-1; REF1; REF1 protein;
Storage
Rabbit IgG in phosphate buffered saline , pH 7.4, 150mM NaCl, 0.02% sodium azide and 50% glycerol. Store at -20 °C. Stable for 12 months from date of receipt.
Swissprot
P27695




 产品订购:
产品订购:
 渠道电话:
渠道电话: